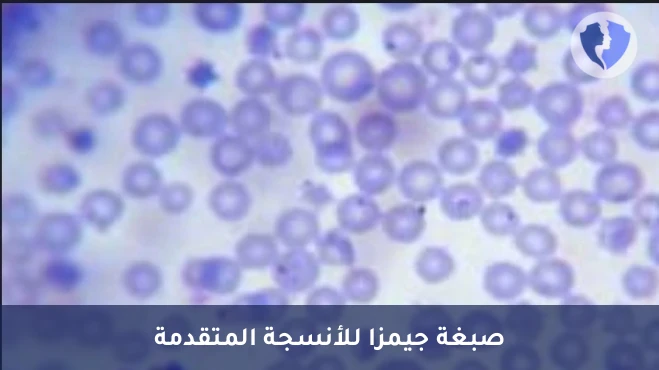
صبغة جيمزا للميكروبات - صبغة جيمزا النسيجية (Giemsa Stain)

تفاصيل الخدمة
صبغة جيمزا للميكروبات - صبغة جيمزا النسيجية (Giemsa Stain)
جيمزا هي صبغة معقدة من صبغتي الأزرق الميثيلين والأيوسين تُستخدم في علم الأحياء الدقيقة وعلم الأنسجة. تعمل على تلوين المكونات الحمضية (مثل سيتوبلازم الخلايا، بعض البكتيريا) باللون الأحمر إلى الوردي، والمكونات القاعدية (مثل نواة الخلايا، الحمض النووي للطفيليات، بعض البكتيريا) باللون الأزرق إلى البنفسجي. تُعد الطريقة المفضلة للكشف عن طفيليات الملاريا في مسحة الدم السميكة والرقيقة.